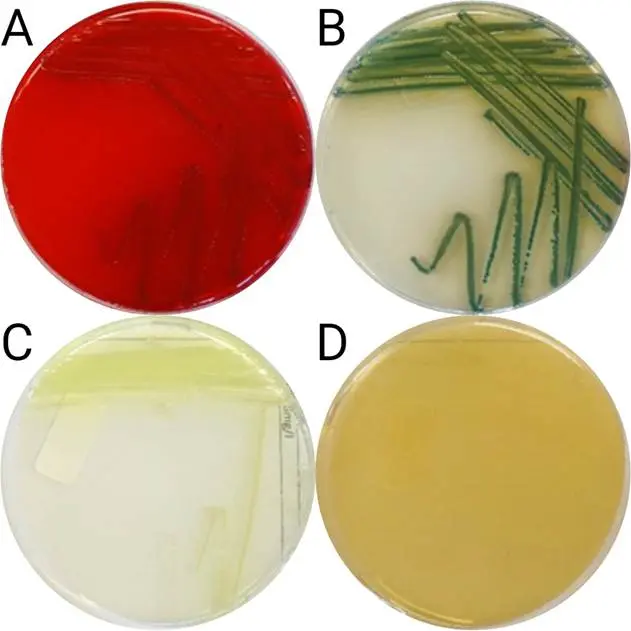
菌株4在不同琼脂平板上的形态学,含亚米佩南(A: M-PA-C;B:克罗玛加尔;C:CN琼脂;D:mZ-琼脂) 菌株4在不同琼脂平板上的形态学,含亚米佩南(A: M-PA-C;B:克罗玛加尔;C:CN琼脂;D:mZ-琼脂)
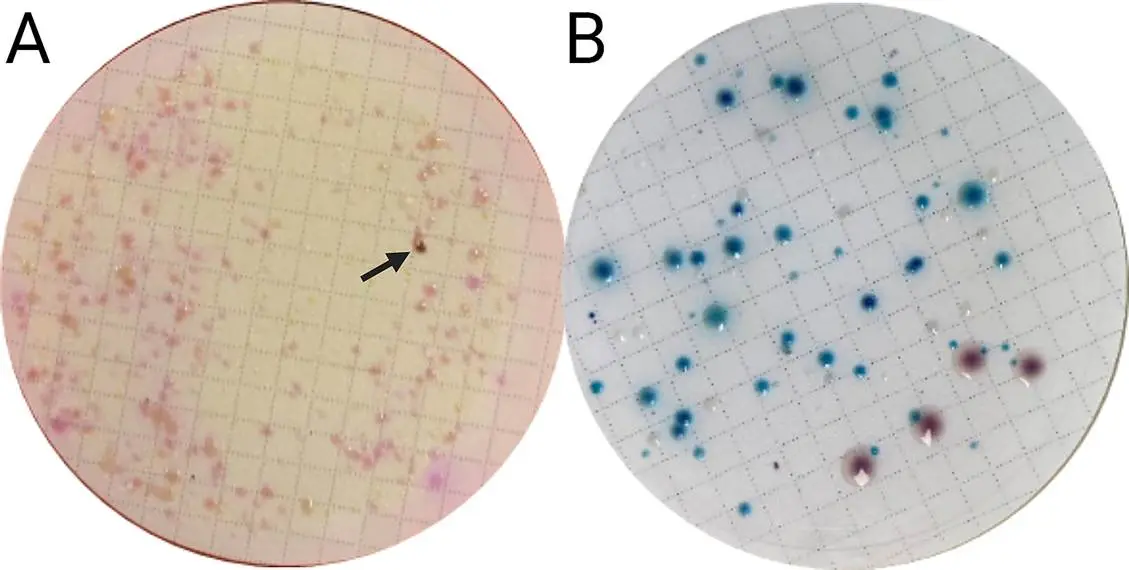
使用3毫升废水样本,使用亚美南(IMIPENEM)在M-PA-C(A)和CHROMagar(B)上建立菌落 使用3毫升废水样本,使用亚美南(IMIPENEM)在M-PA-C(A)和CHROMagar(B)上建立菌落

地表水和废水中碳青霉烯类耐药铜绿假单胞菌的检测方法
发布时间:2025-12-22 浏览次数:70
1.引言
水体作为铜绿假单胞菌的重要储存库,普遍存在该菌污染,其形成的生物膜难以清除,且耐药性问题日益严峻,特别是碳青霉烯类耐药铜绿假单胞菌(CRPA),被世界卫生组织列为高优先级病原体,可引发难治性感染。然而,现有检测方法多针对临床样本,缺乏适用于水体的标准化方案,且传统ISO方法存在灵敏度低、耗时长、选择性差等问题。因此,开发一种高效、特异的CRPA水体检测方法,对环境监测和公共卫生防控至关重要。
本研究开发了针对水体中碳青霉烯类耐药铜绿假单胞菌(CRPA)的标准化检测技术,通过系统优化培养基组合、富集策略及抗生素添加方式解决了传统方法背景干扰大、特异性差的问题。实验采用膜过滤浓缩水样后,比较四种选择性培养基(M-PA-C、CHROMagar等)在添加亚胺培南(8 mg/L)、美罗培南等抗生素下的菌株回收率,结合非选择性富集(天冬酰胺脯氨酸肉汤+万古霉素)与选择性平板培养(添加亚胺培南),显著提升CRPA检出率。通过加标地表水与天然污染废水样本验证,该方法将背景菌抑制的阳性预测值(PPV)提升至80–100%,检测限低至3.91 CFU,解决了环境水体CRPA监测灵敏度不足的瓶颈,为耐药性传播追踪提供了可靠工具。
2.结果与讨论
选择性培养基上CRPA菌落形态:展示了7株特征明确的CRPA在四种培养基(CN琼脂、M-PA-C、CHROMagar、mZ琼脂)补充亚胺培南后的菌落表型。M-PA-C和CHROMagar能清晰显示典型菌落形态(如M-PA-C的粉红色菌落、CHROMagar的蓝绿色菌落),而mZ琼脂因菌落透明度高导致识别困难。值得注意的是,CN琼脂中部分菌株(如Strain 2、3)在亚胺培南存在下生长受抑制。
图 1 菌株4在不同琼脂平板上的形态学,含亚米佩南(A: M-PA-C;B:克罗玛加尔;C:CN琼脂;D:mZ-琼脂)。
地表水加标样品直接平板的菌落变化:对比了CRPA菌株在地表水直接过滤培养后的形态变化。所有菌株在M-PA-C上呈粉红色典型菌落,但在CHROMagar上出现色素褪变(蓝绿色菌落变为棕灰色透明),且Strain 6在含头孢他啶的培养基中生长不良。未加标样品中,非选择性TSA平板背景菌落>100,而选择性平板背景显著降低。

图 2 地表水(100 mL)在M-PA-C(A)上加入了Strain 5(100 CFU)和CHROMagar(B)与亚米佩南。
废水样品直接平板的假阳性现象:揭示了废水直接平板的鉴定误差问题。在M-PA-C+亚胺培南平板上,CRPA呈黄褐色菌落(箭头所示),而CHROMagar的蓝色菌落经质谱鉴定均为 Aeromonas caviae 等非铜绿假单胞菌(假阳性率100%)。该结果说明直接平板难以区分表型相似的环境菌。
图 3 使用3毫升废水样本,使用亚美南(IMIPENEM)在M-PA-C(A)和CHROMagar(B)上建立菌落。在这块特定的M-PA-C板上,有1株抗碳青霉烯的铜绿假单胞菌(CRPA;用箭头标记)。在CHROMagar上,即该特定板块,既未发现CRPA也未发现P. aeruginosa。CHROMagar上的所有蓝色殖民地都是其他物种。
废水背景菌的物种分布:通过MALDI-TOF质谱鉴定,统计了直接平板法中非目标菌的物种组成。Aeromonas spp.(占58%)和Pseudomonas oleovorans(占21%)是主要干扰菌,在CHROMagar上形成拟似CRPA的蓝色或绿色菌落,导致假阳性预测值(PPV)仅0-30%

图 4 在M-PA-C和CHROMagar废水直接镀层时,配合抗生素进行假阳性物种鉴定。
不同方法的菌种检出比例:量化比较了直接平板与富集法对目标菌(CRPA/CSPA)和非目标菌的分离效率。直接平板中非铜绿假单胞菌占比高达60-90%(如CHROMagar-美罗培南组),而富集法(ASP+万古霉素→M-PA-C+亚胺培南)将CRPA检出比例提升至73%,背景菌降至<10%。

图 5 在直接对M-PA-C和CHROMagar进行废水直接镀层时发现的所有疑似菌落的比例,以及加抗生素的假单胞菌和铜质假单胞菌的比例。CRPA:碳青霉烯耐药性铜绿假单胞菌;CSPA:对碳青霉烯敏感的铜绿假单胞菌。
3.总结
该研究建立了首个针对水环境中耐碳青霉烯类铜绿假单胞菌(CRPA)的标准检测方法,其核心优势在于系统性优化与实际应用适配性。通过对比四种选择性培养基与多种抗生素组合,创新性采用“过滤浓缩→非选择性富集(ASP+万古霉素)→选择性平板(M-PA-C+亚胺培南)”三步流程,显著提升检测灵敏度(最低检出限达7.20×10² CFU)与特异性(PPV 73%)。方法有效抑制废水背景菌干扰(如 Aeromonas spp.),克服传统ISO方法耗时长、假阳性率高的缺陷。研究同步验证了亚胺培南(8 mg/L)作为最优选择剂,且明确富集步骤添加抗生素会降低检出率,为环境耐药菌监测提供了关键技术支持。
论文链接:https://doi.org/10.1016/j.scitotenv.2024.178086
来源:微生物安全与健康网,作者~牛婧媛。











